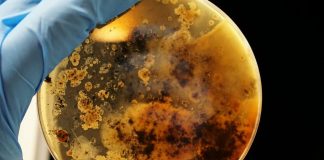
#MUNDO Uso de antibióticos en animales es una amenaza a la salud global

POST POPULARES
SOBRE NOSOTROS
Somos el portal de noticias animalistas y medio ambientales del Equipo de Protección Animal Chile (EPA), dejando huellas por los animales. Nuestro objetivo es dar a conocer toda la actualidad de tu región, Chile y el mundo en un solo lugar: www.epanews.cl de un modo veraz, dinámico y actualizado.
Contactanos: contacto@epanews.cl
© Epa News 2020 Power By Salto Digital